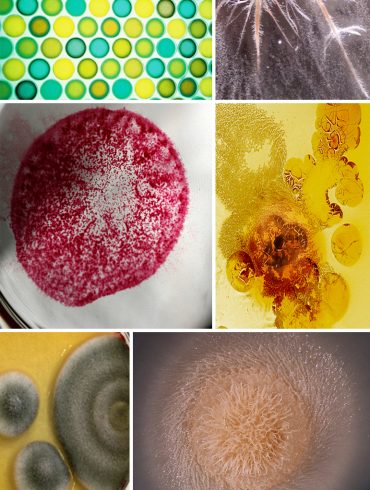

Photo credits (clockwise): (1) Devil’s Throat, Garganta del Diablo by GiselaGiardino (2) Water and Ink by Raj (3) Ingleton, North...
*images (clockwise): “Sand on Cobbles” by Ed Townend, “Shadow Patterns” by Mike Baird, “Sand Ripples” by Kelly Cookson, “Sand Ribs”...
*images(from clockwise): “Fallen Cherry Blossoms” by Chris Willis, “Cherry Blossoms” by Khairil Zhafri, “Cherry Blossom Pink” by ErrorTribune, “Petals” by...
* post by Jennifer Herrmann, images via: “Petri Dishes” by Slimmer Jimmer, “Typhula Incarnata Sclerotia” by Seraph of Lies, “Last...
Images via: (clockwise from top left) “Hillcrest Farmers Market” by Rob Bertholf (cropped from original), untitled photo by j bizzie (cropped from original), “Kale” by Quinn Dombrowski, “11/52 – Beauty in the...
Images via: (clockwise from top left) “Many colored straws thrown on top of each other” by Horia Varlan (cropped from original), “the merry family” by batintherain (cropped from...
*images (clockwise): “Texture” by Virginie Moerenhout, “Leaf” by Mike Bostock, “Leaf Skeleton” by Jonathan Wilson, “Sycamore Leaf” by Scott Robinson,...
Images via: (clockwise from top left) “DSC_7970” by Cha già José (cropped from original), “Heather cranberry farms” by Sam Beebe (cropped from original), “The Golden Sea” by Ian Sane, “farm equipment” by Jennifer Boyer, “PhoTones...
*post by The Pattern Observer team, images via: “Untitled” by Daniel Oines, Hermes Spring ’13 via style.com, “Untitled” by Daniel...
* images via: Gucci Pre-Fall ’12: Style.com, “Places You’ve Been To” by Robert Donovan, “Love is patient, love is kind”...
*post via Rita Jardón, images via: “Two weights and Twine” by Psyberartist, “Rope and two poles” by Psyberartist, “Knowing the ropes” by Psyberartist, “Rope Macro” by...
*images via: “Indigo Bunting” by Hurt_Curt, “Unknown”by Michael, “Blue Tile” by Patrick Hoesly, “Blue Moon Texture” by Dyrk Wyst, “Indigo...